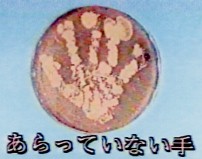
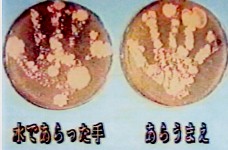

|
 |
| ‚P | ‚Q |
 |
 |
| ‚RЃF‚T•b€И“а‚МЋиђф‚ў‚Е‚НЃA‹p‚Б‚Д ‹Ы‚Є‚У‚¦‚й‚»‚¤‚Е‚·ЃB |
‚SЃFђО‚Ї‚с‚р‚В‚Ї‚Д‚К‚й‚К‚й‚Є‚Ж‚к‚й‚Ь‚Е Ѓ@Ѓ@ђф‚ў‚Ь‚µ‚傤ЃB |
 |
 |
| ‚T | ‚U |
 |
 |
| ‚VЃF‚b‚fЃB‹Ы‚ЄЋџЃX‚Й‘ќ‚¦‚Д‚ў‚«‚Ь‚·ЃB | ‚W |
 |
 |
| ‚X | ‚P‚O |
 |
 |
| ‚P‚P | ‚P‚Q |
 |
 |
| ‚P‚R | ‚P‚SЃF‚Ё‚µ‚Ь‚ў |
ЋАЌЫ‚ЙЌмђ¬‚µ‚Ѕ‚u‚s‚q‚М‰f‘њ‚Е‚·ЃB
ЏЪЌЧ‚НЃAЃu‚©‚з‚ѕ‚МЉwЏKЃEѓ~ѓjЋw“±Ѓi‰єЃjЃv‚Й‚ДЃEЃEЃEЃB
 |
 |
| ‚P | ‚Q |
|
 |
| ‚RЃF‚T•b€И“а‚МЋиђф‚ў‚Е‚НЃA‹p‚Б‚Д ‹Ы‚Є‚У‚¦‚й‚»‚¤‚Е‚·ЃB |
‚SЃFђО‚Ї‚с‚р‚В‚Ї‚Д‚К‚й‚К‚й‚Є‚Ж‚к‚й‚Ь‚Е Ѓ@Ѓ@ђф‚ў‚Ь‚µ‚傤ЃB |
 |
|
| ‚T | ‚U |
 |
 |
| ‚VЃF‚b‚fЃB‹Ы‚ЄЋџЃX‚Й‘ќ‚¦‚Д‚ў‚«‚Ь‚·ЃB | ‚W |
 |
 |
| ‚X | ‚P‚O |
 |
 |
| ‚P‚P | ‚P‚Q |
 |
 |
| ‚P‚R | ‚P‚SЃF‚Ё‚µ‚Ь‚ў |